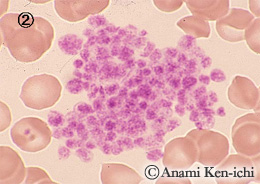
2

血球計数装置における血小板阻害因子にあげられるものです。
対処法として、@とCは再採血、AとCはEDTAを除くヘパリンやクエン酸ナトリウム加血などを用いて対処しますが、決定的なものはないようです。
![]() |
![]() |
| 採血不良にてフィブリン糸が析出し、そこに血小板が付着したようです。偽性血小板減少症を呈しますが白血球数も不安定になります。 | EDTA(抗凝固剤)による血小板凝集塊です。 EDTA存在下で患者血清中に血小板凝集素IgG抗体が存在するためと考えられています。 |
![]() |
![]() |
| 好中球の周囲に血小板が付着した血小板衛星現象で偽性血小板減少症を呈します。EDTA存在下でIgG型の凝集素の存在が原因とされていますが不明です。 | 採血不良にて血管内皮細胞が剥がれて出現したものでその周囲には血小板が付着して偽性血小板減少症を呈します。 また内皮細胞は白血球にカウントされ偽性白血球増加症を呈します。 |